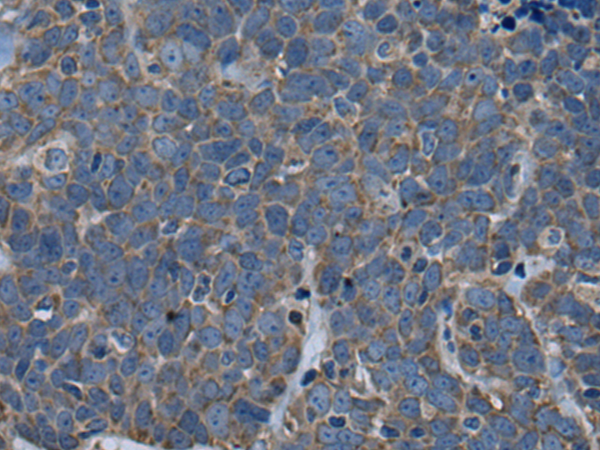

|
Background: |
ADP-ribosylation factors (ARFs) play an important role in intracellular vesicular trafficking. The protein encoded by this gene is involved in the activation of ARFs by accelerating replacement of bound GDP with GTP. It contains a Sec7 domain, which may be responsible for guanine-nucleotide exchange activity and also brefeldin A inhibition. |
|
Applications: |
ELISA, IHC |
|
Name of antibody: |
ARFGEF1 |
|
Immunogen: |
Synthetic peptide of human ARFGEF1 |
|
Full name: |
ADP ribosylation factor guanine nucleotide exchange factor 1 |
|
Synonyms: |
BIG1; P200; ARFGEP1 |
|
SwissProt: |
Q9Y6D6 |
|
ELISA Recommended dilution: |
5000-10000 |
|
IHC positive control: |
Human thyroid cancer and human tonsil |
|
IHC Recommend dilution: |
20-100 |

購物車
購物車 幫助
幫助
 021-54845833/15800441009
021-54845833/15800441009
